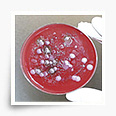

11-10-2010
Группа учёных из Института Фраунгофера занимается выращиванием алмазов, но не в целях личного обогащения, а для того, чтобы покрыть ими электроды и разработать технологию очистки сточных вод. Электроды могут очищать воду и без применения алмазов. При размещении двух электродов в воде и пропускании электротока образуются окислители, такие как озон и гидроксильные радикалы.

06-10-2010
Вслед за студенческим объединением университета Торонто, студенческий союз университета Йорка начал кампанию "Кампус, свободный от бутилированный воды". Студенты надеются постепенно отойти от использования пластиковых бутылок на территории кампуса. YFS начинает кампанию в сотрудничестве с Канадской федерацией студентов (CFS), которая предоставляет необходимые информационные материалы.

06-10-2010
Клер О'Реган, член городского совета Дублина считает, что городу следует восстановить вышедшие из строя общественные питьевые фонтанчики и агитировать жителей к их использованию. Клэр убеждает городской совет возобновить работу общественных питьевых фонтанчиков и предоставить людям доступ к чистой, безопасной и бесплатной питьевой воде.

06-10-2010
Посудомоечные машины требуют затрат на электричество, воду и чистящие вещества. Компания Classeq, ведущий английский производитель посудомоечных машин, составила список из 6 самых действенных советов, благодаря которым организации и частные лица могут экономить значительные суммы.

04-10-2010
В начале апреля 2010 года состоялось официальное открытие очистной станции большой мощности, через несколько дней жители Санд-сити, страдавшие от жажды, получили доступ к опреснённой океанской воде. По словам Scientific American, городские власти заявили, что разницу между опреснённой водой и той, что поставляется из резервуаров, практически невозможно ощутить.

02-10-2010
1 сентября 2010 года сотни тысяч людей на юге Калькутты, в Гарден Рич и Бехале остались без воды из-за поломки мощного насоса на очистной станции в Гарден Рич. Согласно официальным сведениям от компании KMC, поставщика услуг в сфере водоснабжения, утром в среду в южной Калькутте наблюдалась нехватка 24 миллионов галлонов воды (примерно 90 млн. литров).

30-09-2010
Инициатива решения проблемы с водой принадлежит Ассоциации врачей пакистанского происхождения, которая расположена в американских штатах Кентукки и и Индиана. Изначально группа надеялась собрать средства на четыре установки по очистке воды, разработанные специально на случай стихийных бедствий.

03-10-2010
Когда Рэймонд Ли решил создать реактивный ранец, работающий на выбросе воды, а не на ракетном топливе, большинство его друзей сказали ему, что он сумасшедший. Вдобавок к этому, инженеры уверяли его, что массы воды и тяги водяной струи будет недостаточно для стабильной работы устройства.

03-10-2010
Согласно отчёту Всемирного банка о рациональном использовании водных ресурсов в мире, Ботсвана может получить помощь в осуществлении проекта по повторному использованию сточных вод. Правительство рассчитывает, что первые порции питьевой воды поступят для нужд Габароне - столицы Ботсваны - к 2013 году.

03-10-2010
Утилизации отходов - одна из главных проблем индустриального общества. Даже когда отходы подвергаются обработке, происходит загрязнение окружающей среды. Проблема остаётся и в случае, когда отходы разлагаются и естественным образом. Отходы в процессе естественного разложения не только источают зловоние, они загрязняют воздух.

03-10-2010
Установка CrystalBallast, размещённая на судне, была спроектирована компанией Auramarine Ltd, производителем систем подачи топлива для кораблей. Auramarine базируется в финском городе Турку и является дочерним предприятием Hollming Group. Подобные системы не позволяют организмам, которые содержатся в воде одного моря, попадать в воды другого моря, нарушая экологическую обстановку.

30-09-2010
Litree Company, поставщик воды для Всемирной выставке в Шанхае, на днях объявила о расходе воды во время проведения мероприятия. На конец августа для функционирования Выставочного зала потребовалось 105 тысяч тонн питьевой воды. В течение четырёх месяцев участники и посетители Всемирной выставки в Шанхае имели доступ к питьевой водопроводной воде.
30-09-2010
Обитатели равнины Тераи, расположенной на юге Непала, медленно отравляют свой организм употреблением воды с примесями мышьяка. Благотворительные организации раздают домохозяйствам в этой области 37 тысяч фильтров, избавляющих воду от этих примесей.

23-09-2010
Трёхлетнее переустройство стадиона Мичиганского университета, на которое потребовалось 226 миллионов долларов, закончилось в начале сентября 2010 года. Посетителей ждут значительные изменения. На обновлённом стадионе установлены 24 новых питьевых фонтанчика.

23-09-2010
Вода есть практически в любом уголке Земли, но в промышленно-развитых регионах или тех, что пострадали от стихийных бедствий (как например, Пакистан от недавнего наводнения), поиск чистой воды выливается в большую проблему. Обычно питьевую воду в таких регионах получают с помощью фильтров, вылавливающих бактерии из потока воды.

19-09-2010
В настоящий момент ведение собственного малого бизнеса - нелёгкая задача. Предприниматель вынужден лавировать между растущими затратами на коммунальные услуги и заработной платой работникам, при этом бороться за клиентскую базу с конкурентами, контролируя каждый заработанный рубль.

27-08-2010
Установки от EnviroTower будут поставляться во все новые магазины, включая девять магазинов, открывающихся в сентябре в Калифорнии. Экологически безопасные, надёжные очистные установки уже установлены в 37 супермаркетах Fresh&Easy.

19-09-2010
Городской совет Шеффилда, в целях улучшения состояния с автотранспортом в городе, предпринял попытку запустить по дорогам автомобили на биотопливе из канализации. Речь идёт о шести фургонах, топливом для которых будет газ, полученный в результате очистки канализационных стоков.